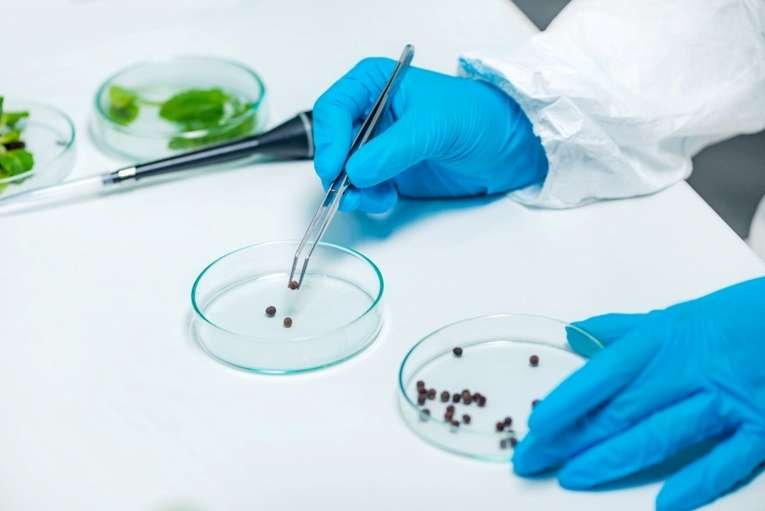

Equipping Researchers in the Developing World
Lorem ipsum dolor sit amet, consectetur adipiscing elit, sed do eiusmod tempor incididunt ut labore et dolore magna aliqua. Felis donec et odio pellentesque diam volutpat commodo sed egestas. At [...]
Should We Trust Computer-Aided Weapons Modeling?
Lorem ipsum dolor sit amet, consectetur adipiscing elit, sed do eiusmod tempor incididunt ut labore et dolore magna aliqua. Felis donec et odio pellentesque diam volutpat commodo sed egestas. At [...]

Book Review: Clinical Research Compliance Manual
Lorem ipsum dolor sit amet, consectetur adipiscing elit, sed do eiusmod tempor incididunt ut labore et dolore magna aliqua. Felis donec et odio pellentesque diam volutpat commodo sed egestas. At [...]

7 Materials that Are Set to Change the Building Industry
Lorem ipsum dolor sit amet, consectetur adipiscing elit, sed do eiusmod tempor incididunt ut labore et dolore magna aliqua. Felis donec et odio pellentesque diam volutpat commodo sed egestas. At [...]

10 Cool Jobs in Science You Didn’t Know Existed
Lorem ipsum dolor sit amet, consectetur adipiscing elit, sed do eiusmod tempor incididunt ut labore et dolore magna aliqua. Felis donec et odio pellentesque diam volutpat commodo sed egestas. At [...]
